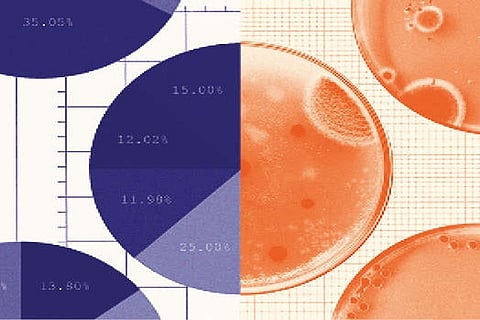
A balancing act: Bridging economists and epidemiologists

Chennai
So it’s good that there’s a new effort to reconcile them. It takes the form of a manifesto released by 11 scholars this month: a National Bureau of Economic Research working paper with the subtitle “Bringing Epidemiologists and Economists Together.”
The conventional wisdom is that when it comes to policy prescriptions, economists put more weight on keeping the economy from shutting down, while epidemiologists put more weight on saving lives. That’s an oversimplification, of course, but there’s some truth in it. “It’s an article of faith for economists that there is no such thing as an absolute value — not even the value of human life,” Noah Feldman, a law professor at Harvard, wrote in a Bloomberg opinion column last year.
What is clear is that the two disciplines’ models don’t line up: Each group emphasises the part that it’s good at. The new working paper, whose authors are a mix of economists, epidemiologists and experts in related fields, notes that “a reasonable critique of most economic models” is that they make “strong and unrealistic assumptions” about disease transmission that neglect the diversity of individual cases. But “a reasonable critique of most epidemiological models,” the paper continues, is that they fail to properly consider the sort of cost-benefit calculations that predictably influence how people behave in the face of health risks.
So why not just mash up the models, combining the rich detail of each to create something that’s greater than the sum of its parts? It’s a good idea but not easy, in part because it can make a model too complex. Consider this intricate cycle: Covid-19 hits, so people stop working, so they spend less. As a result, demand for labor falls, so wages fall, so even more people stay at home … so infection rates decline. Models of individual behavior that incorporate such feedback loops are sometimes “difficult to solve even with vast amounts of computing power,” the authors write. This week I interviewed three of the authors to learn more about where this new effort came from and where it’s headed. The three are based at Johns Hopkins University in Baltimore, as are five of the other contributors.
Nicholas Papageorge, an economist, explained that he initiated the effort last year because he felt that some people weren’t taking the economic harms caused by the pandemic shutdowns seriously enough. “The conversation seemed to be about sourdough starter and catching up on Netflix,” he said. “I was deeply frustrated.” He and Robert Barbera, a former Wall Street economist now at Johns Hopkins, wrote a blog post with a Johns Hopkins epidemiologist, David Dowdy, about how the two groups needed to stop talking past each other. It criticised the “facile story line” that the two groups were necessarily at odds. “Any hope of constructing an intelligent plan for the U.S. populace in the months ahead will require thoughtful collaboration, not conflict, between public health and economics professionals,” the post said.
“No one had sat down and said, ‘Why do we not seem to like each other very much?’” Papageorge recalled. “We just hunker down in our silos and say the other group’s dumb.”
He and another economist, Michael Darden at Johns Hopkins’s Carey Business School, got a grant from the Hopkins Business of Health Initiative to conduct six hours of frank discussions between economists and epidemiologists this past summer. One strong conclusion of the group was that there really is a balance that must be struck between health and wealth, between lives and livelihoods.
Coy is an Opinion Writer with NYT©2021
The New York Times
Visit news.dtnext.in to explore our interactive epaper!
Download the DT Next app for more exciting features!
Click here for iOS
Click here for Android